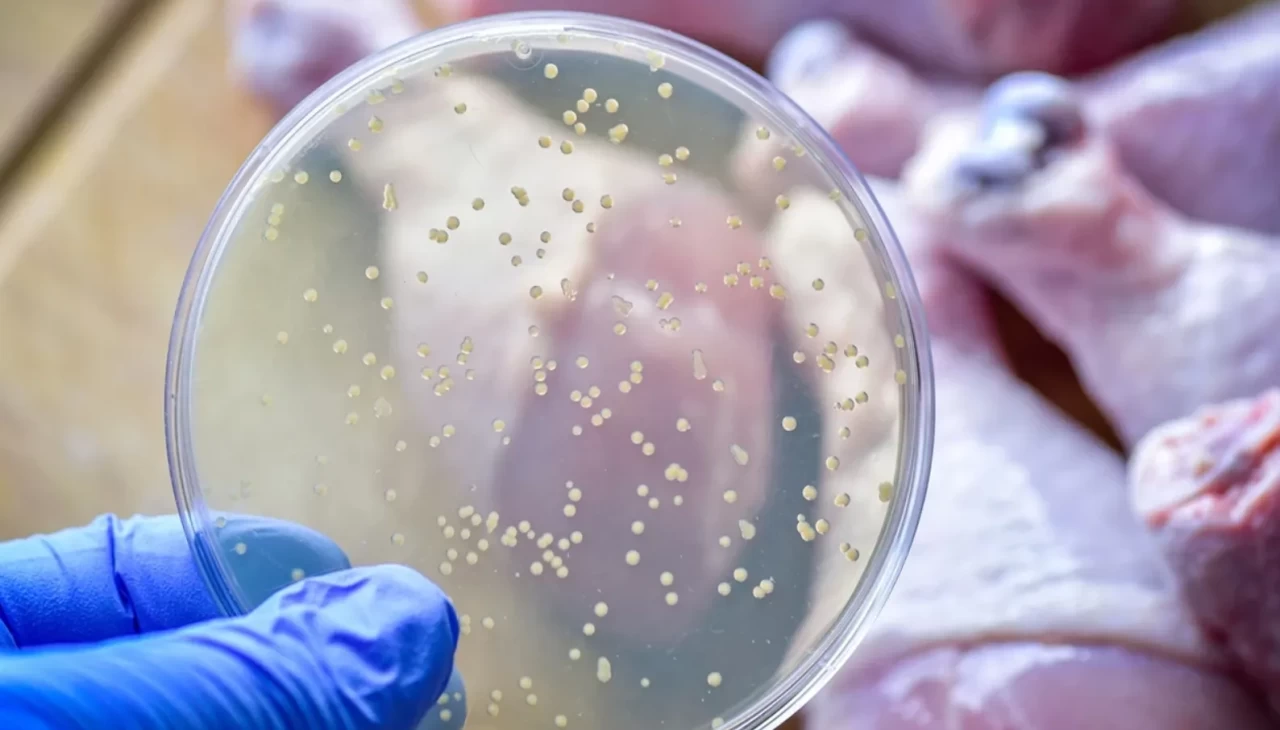

Birçok kişi mutfağında her şeyi doğru yaptığını düşünür ama aslında en büyük tehlike gözle görülmeyen detaylarda saklıdır. Buzdolabına koyma süresi, kesme tahtasının kullanımı ya da yemeğin ne kadar piştiği gibi basit görünen alışkanlıklar, fark edilmeden sağlığı etkileyebilir.
Uzmanların yıllardır altını çizdiği bir gerçek var: Gıda güvenliği, sadece malzemenin kalitesiyle değil, mutfakta gösterilen özenle belirleniyor. İşte tam da bu yüzden, günlük hayatta kolayca uygulanabilecek dört temel kural öne çıkıyor.

AYIR: Aynı tahtada yapılan küçük hata büyük risk
Mutfakta en sık gözden kaçan konulardan biri, çiğ ve pişmiş gıdaların birbirine temas etmesi. Örneğin çiğ tavuk doğradığınız bıçakla salata kesmek, fark etmeden bakterileri doğrudan sofraya taşımak anlamına geliyor.
Bu yüzden çiğ et, tavuk ve sebzeler için ayrı kesme tahtaları kullanmak, basit ama etkili bir alışkanlık haline getirilmeli. Küçük bir dikkat, büyük bir riski ortadan kaldırabiliyor.
TEMİZLE: Sadece durulamak yetmiyor
Birçok kişi sebzeyi yıkayıp geçmenin yeterli olduğunu düşünse de asıl önemli olan mutfak genelinde hijyenin sağlanması. Eller, tezgahlar ve kullanılan ekipmanlar temiz değilse, yıkanan gıdanın da güvenliği tartışmalı hale geliyor.
Yemek yapmadan önce ve çiğ ürünlerle temas sonrası elleri sabunla yıkamak, mutfakta hijyenin en temel adımlarından biri olarak kabul ediliyor.

PİŞİR: Görünüşe aldanmak en sık yapılan hata
Yemeğin dışı kızarmış olabilir ama bu her zaman içinin tamamen piştiği anlamına gelmez. Özellikle et ve tavuk ürünlerinde iç kısmın yeterince ısıya ulaşması gerekiyor.
Yeterince pişmeyen gıdalar, fark edilmeden tüketildiğinde sağlık sorunlarına yol açabiliyor. Bu nedenle pişirme süresi ve sıcaklığı, mutfakta en az lezzet kadar önemli bir konu haline geliyor.
SOĞUT: En kritik detay çoğu zaman burada kaçıyor
Pişmiş yemeği uzun süre tezgahta bekletmek, en sık yapılan hatalardan biri. Oysa oda sıcaklığı, bakterilerin en hızlı çoğaldığı ortam olarak biliniyor.
Yemeklerin mümkün olduğunca hızlı şekilde soğutulup buzdolabına kaldırılması gerekiyor. Özellikle “biraz dursun sonra koyarım” alışkanlığı, fark edilmeden riski büyütebiliyor.

Küçük alışkanlıklar sofrayı koruyor
Mutfakta yapılan her hareket, aslında doğrudan sağlığı etkiliyor. Büyük değişikliklere gerek kalmadan, sadece doğru alışkanlıklar edinerek daha güvenli bir mutfak ortamı oluşturmak mümkün.
Dikkatli bir hazırlık, doğru pişirme ve bilinçli saklama ile sofradaki görünmeyen riskler büyük ölçüde kontrol altına alınabiliyor.